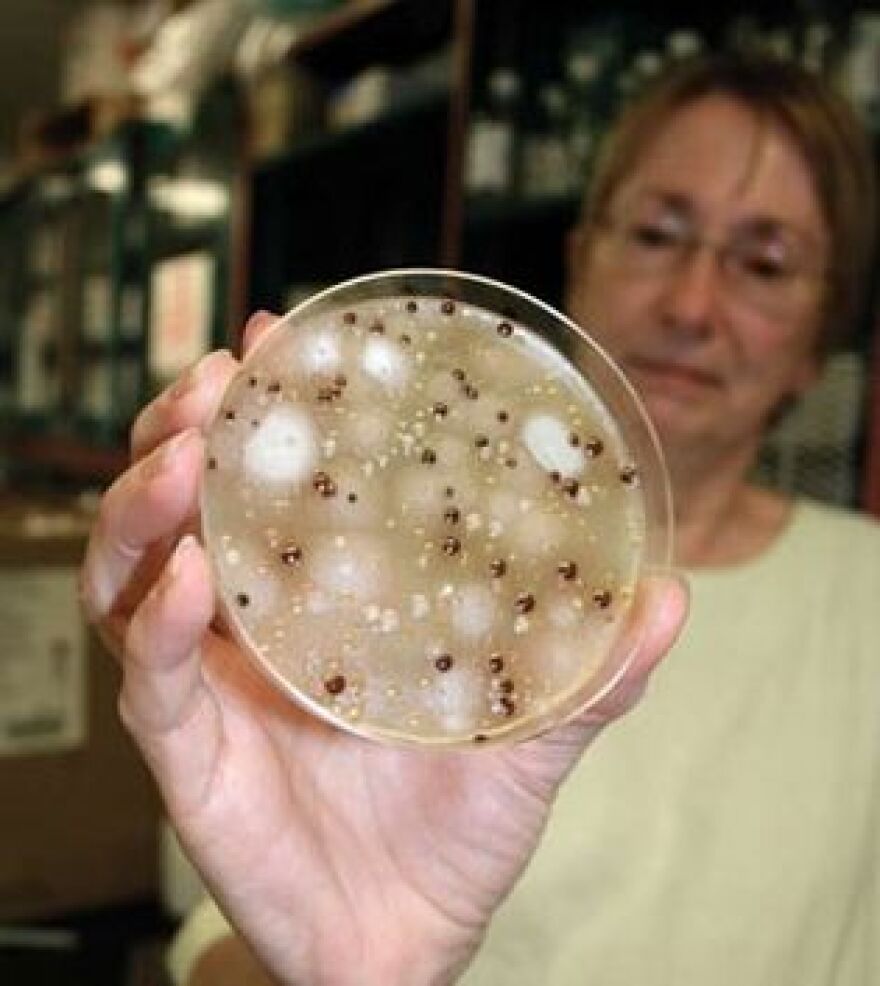

Scientists are studying the DNA of a deadly tropical fungus to learn how it is able to adapt in a foreign environment. Cryptococcus gattii is believed to have originated in the jungles of Brazil, but has been making people sick in the Pacific Northwest of the United States for about 20 years. David Engelthaler, the director of TGen in Flagstaff, wants to know how strains of the fungus are evolving and spreading disease.
“So by studying the genes and studying the mutations, we can start to understand how different a fungus that shows up in places like Vancouver or the Seattle area, how different that is from its cousin that’s down in, say, the middle of the Amazon rain forest. By doing that we can start to identify clues as to how old it is, how old this population is up in the Pacific Northwest. What gene differences might be there that makes it even deadlier or allows it to survive in this very different habitat,” he says.
The fungus is believed to have traveled to North America on ships, after the creation of the Panama Canal—about 80 years ago. Engelthaler says it attacks the lungs and sometimes the brains of people with compromised immune systems.
“This ongoing research to understand what changes in the genome, in the DNA, allowed it to move and survive are going to hopefully give us not only better information for diagnostics so that we can quickly detect these new strains and quickly determine if they are showing up in other parts of the world,” he says.
By better understanding the fungus, Engelthaler says researchers may be able to develop new drugs to fight the serious infections it causes in at-risk populations and prevent deaths in the future.